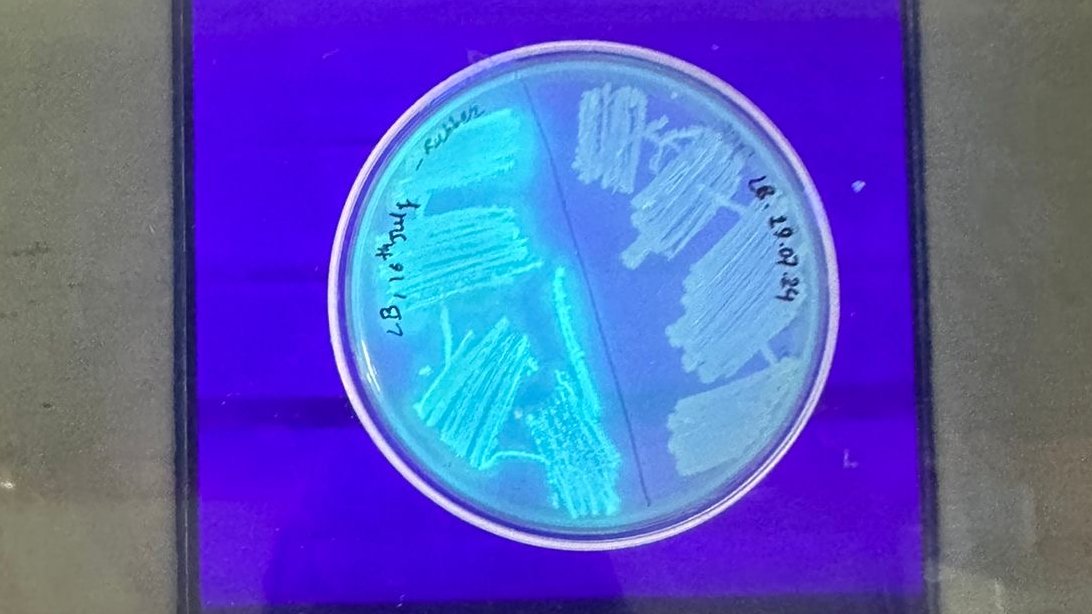
DoerrLab's tweet image. And that concludes our workshop in Nepal! Successfully cloned NDM carbapenemases? Check! Isolated bacteria that can eat styrofoam and motor oil from Bagmati River AND fluoresce under UV? Check! @rajbhandari_33 @karmamonima @guavadk @utsavRIBB @AnkitSh03786959

Doerr Lab
@DoerrLab
We study how bacteria build and maintain a healthy cell envelope and resist killing by antibiotics.
你可能會喜歡
Baskin Lab researchers have uncovered the surprising role played by a “three-tailed” fat molecule in cellular survival during heart attack and stroke: protecting the cells against damage when oxygen runs out. news.cornell.edu/stories/2025/0…
Research led by @weillinstitute postdoctoral fellow Megan Keller in @DoerrLab reveals how sugar-phosphate buildup disrupts cell wall synthesis, offering clues to fight drug resistance. news.cornell.edu/stories/2025/0…
We’re thrilled to announce our Weill Institute 2025 Emerging Scholars –– eight outstanding grad students & postdocs selected for their innovative research, from institutions across the US and Canada. We'll welcome them to Cornell’s campus Oct 13–14, 2025. bit.ly/45f5GwQ

Molecular mechanism revealed for bacterial sugar overload. doi.org/10.1128/mbio.0… @MRKmicrobes @DoerrLab

Tissue-Like Multicellular Development Triggered by Mechanical Compression in Archaea biorxiv.org/cgi/content/sh… #biorxiv_cellbio
📢 Attention antibiotic tolerance researchers! Our GIANT review of 50+ years' of clinical antibiotic tolerance data is now available online in Clinical Microbiology Reviews. Check it out here: journals.asm.org/eprint/UUSIDYA… @ASMicrobiology @Hobbs_Lab_Micro @DeventerAshley @microclaire

Congratulations to Dr. Manuela Alvarado Obando for an amazing PhD defense seminar! Felicidades, and on to more greatness! @CornellMicrobio @ManuelaAlv95 dx.plos.org/10.1371/journa… If you are looking for an exceptional postdoc (and are in the greater NYC area), reach out to her!

Latest preprint from our lab led by grad student @cassidyprints and her undergrad mentee @IsabellaNLin. She examines conservation and features of the programmed ribosomal frameshift in prfB. Presented by Cassidy at #GRC stress! biorxiv.org/content/10.110…
What a phenomenal seminar today at @CornellPathogen by @Hatzios_Lab — a tour de force of using chemical proteomics to discover new mechanisms of redox signaling in gut infection!🤩🤩🤩


Out now in @NatureComms: Control of bacterial cell wall autolysins by peptidoglycan crosslinking mode @CavaLab_MIMS @FelipecavaM @DoerrLab nature.com/articles/s4146…
Our new paper out in @PLOSPathogens today: dx.plos.org/10.1371/journa… We find that resistance/tolerance to antimicrobial peptides is slightly more complex and dynamic than your "average" antibiotic resistance. Nice work by @AndyMurtha et al.!
We demonstrated a lowcost device that can detect deadly bacteria in drinking water. It shows, once again, that worldclass research can flourish in Nepal, despite limited resources. Here is news release by @OpticaWorldwide highlighting the important result. optica.org/about/newsroom…

Announcing the 2025 Bacterial and Archaeal Cell Biology and Development @GordonConf. We have amazing speakers and discussion leaders confirmed and look forward to (again) having our minds blown by all the remarkable science. Applications will start being accepted in the fall.

And that concludes our workshop in Nepal! Successfully cloned NDM carbapenemases? Check! Isolated bacteria that can eat styrofoam and motor oil from Bagmati River AND fluoresce under UV? Check! @rajbhandari_33 @karmamonima @guavadk @utsavRIBB @AnkitSh03786959

Excited to kick off a bacterial genetics workshop at RIBB Kathmandu! We will be cloning some clinical NDM enzymes. @rajbhandari_33 @karmamonima @guavadk @utsavRIBB @ankitsh03786959 @drakarki


I asked AI to draw an image of the bacterial OM. This is what it came up with. My lab better pivot to the new hot field of outer pemmoccan homeostasis! And how is that one otter equally distributed among daughter cells? Lots of cool open questions!

Huge Congratulations to Dr. Megan Renée Keller @MRKmicrobes for successfully and epically defending her PhD today! #proudPI @Cornell_BBS

What an honor for @cassidyprints and @CornellMicrobio to host Dr. @Nancy_Craig777 for our distinguished Portraits of a Microbiologist series. Thanks for returning to Wing Hall for such a moving and inspiring visit!


@FeagaHeather taking a picture of Portrait of a scientist organizer @cassidyprints and recipient Nancy Craig today! @CornellMicrobio @JoePetersLab

Doerr lab star undergrad Ziyu Xue (@ZiyuXue_ on the right, future graduate student @CornellMicrobio) won the Robert Parker award for best Honors thesis for her work with @CornellMicrobio graduate student @nadia_nikulin (left) Congrats!

United States 趨勢
- 1. Ukraine 483K posts
- 2. Putin 161K posts
- 3. #FursuitFriday 13.1K posts
- 4. #pilotstwtselfieday N/A
- 5. #FanCashDropPromotion 3,656 posts
- 6. Le Cowboy N/A
- 7. #TrumpCrushesYourDreams 4,855 posts
- 8. #FridayVibes 6,943 posts
- 9. Zelensky 98.4K posts
- 10. UNLAWFUL 151K posts
- 11. Kenyon 1,898 posts
- 12. Start Cade N/A
- 13. Abbott Elementary N/A
- 14. Dave Aranda N/A
- 15. John Wall N/A
- 16. Sam LaPorta 1,255 posts
- 17. Mark Kelly 79.1K posts
- 18. NATO 63.6K posts
- 19. Arman 8,911 posts
- 20. Happy Friyay 2,099 posts
Something went wrong.
Something went wrong.


















































































































































